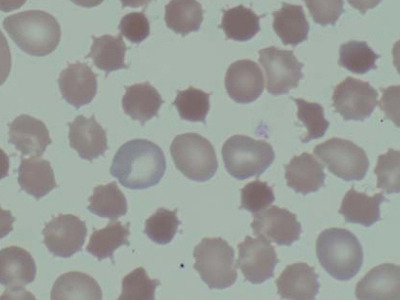

참 쉬운 의학용어사전 (A~K) (L~Z) 통합검색
의학용어 acanthion 앞코가시점, 전비극점
의학용어 acanthion 뜻 앞코가시점, 전비극점 어원 고대 그리스어 ἄκανθα (ákantha, thorn 가시) = 앞코가시점 영어발음기호 əˈkæn.θi.n̩, əˈkænt.θi.n̩, əˈkæn.θiˌɑn 한글발음 어캔띤, 어캔트띤, 어킨띠안 품사 명사 해설 코밑에 있는 머리측정점(두개측정점, craniometric point). 정확히는 앞코가시(전비극, anterior nasal spine)의 끝에 있다. 분야 해부학, 영상의학과, 방사선종양학과
2021. 2. 3.
의학용어 acanthion 앞코가시점, 전비극점
의학용어 acanthion 뜻 앞코가시점, 전비극점 어원 고대 그리스어 ἄκανθα (ákantha, thorn 가시) = 앞코가시점 영어발음기호 əˈkæn.θi.n̩, əˈkænt.θi.n̩, əˈkæn.θiˌɑn 한글발음 어캔띤, 어캔트띤, 어킨띠안 품사 명사 해설 코밑에 있는 머리측정점(두개측정점, craniometric point). 정확히는 앞코가시(전비극, anterior nasal spine)의 끝에 있다. 분야 해부학, 영상의학과, 방사선종양학과
2021. 2. 3.
;